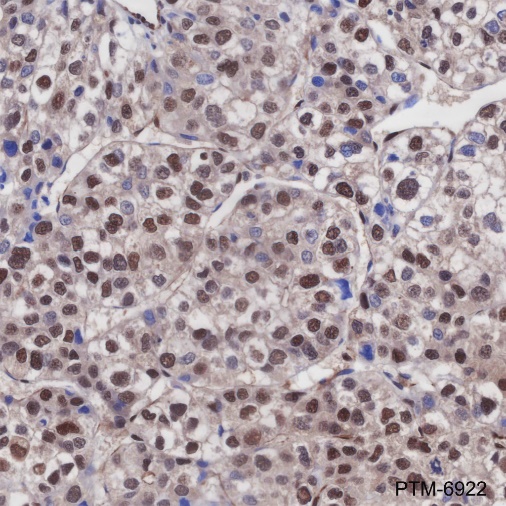

Background
FTO is a DNA and RNA demethylase that catalyzes the oxidative demethylation of thymidine and uracil. Among its targets is an mRNA subset involved in regulation of learning, reward behavior, motor functions, and feeding. Loss of the FTO gene in mice leads to postnatal growth retardation and a significant reduction in adipose tissue. Mice deficient in the FTO gene have lean body mass due to increased energy expenditure and systemic activation of sympathetic neurons, while overexpression of FTO in mice leads to increased food intake and results in obesity. These results demonstrate that FTO is functionally involved in energy homeostasis.
Cellular location
Nucleus, Cytoplasm